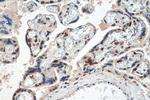
PEG3 Antibody in Immunohistochemistry (Paraffin) (IHC (P))

Search
Proteintech
PEG3 Polyclonal Antibody
{{$productOrderCtrl.translations['antibody.pdp.commerceCard.promotion.promotions']}}
{{$productOrderCtrl.translations['antibody.pdp.commerceCard.promotion.viewpromo']}}
{{$productOrderCtrl.translations['antibody.pdp.commerceCard.promotion.promocode']}}: {{promo.promoCode}} {{promo.promoTitle}} {{promo.promoDescription}}. {{$productOrderCtrl.translations['antibody.pdp.commerceCard.promotion.learnmore']}}
产品信息
23569-1-AP
种属反应
宿主/亚型
分类
类型
抗原
偶联物
形式
浓度
规格
纯化类型
保存液
内含物
保存条件
运输条件
产品详细信息
Immunogen sequence: LNEHMRLHRE DDLLEQSQMA EEAIIPGLAL TEFQRSQTEE RLFECAVCGE SFVNPAELAD HVTVHKNEPY EYGSSYTHTS FLTEPLKGAI PFYECKDCGK SFIHSTVLTK HKELHLEEEE EDEAAAAAAA AAQEVEANVH VPQVVLRIQG LNVEAAEPEV EAAEPEVEAA EPEVEAAEPN GEAEGPDGEA AEPIGEAGQP NGEAEQPNGD ADEPDGAGIE DPEERAEEPE GKAEEPEGDA DEPDGVGIED PEEGEDQEIQ VEEPYYDCHE CTETFTSSTA FSEHLKTHAS MIIFEPANAF GECSGYIERA STSTGGANQA DEKYFKCDVC GQLFNDRLSL ARHQNTHTG
靶标信息
In human, ZIM2 and PEG3 are treated as two distinct genes though they share multiple 5' exons and a common promoter and both genes are paternally expressed. Alternative splicing events connect their shared 5' exons either with the remaining 4 exons unique to ZIM2, or with the remaining 2 exons unique to PEG3. In contrast, in other mammals ZIM2 does not undergo imprinting and, in mouse, cow, and likely other mammals as well, the ZIM2 and PEG3 genes do not share exons. Human PEG3 protein belongs to the Kruppel C2H2-type zinc finger protein family. PEG3 may play a role in cell proliferation and p53-mediated apoptosis. PEG3 has also shown tumor suppressor activity and tumorigenesis in glioma and ovarian cells. Alternative splicing of this PEG3 gene results in multiple transcript variants encoding distinct isoforms.
仅用于科研。不用于诊断过程。未经明确授权不得转售。
篇参考文献 (0)
生物信息学
蛋白别名: ASF-1; granule cell antiserum positive 4; KIAA0287; Kruppel-type zinc finger protein; maternally imprinted; paternally expressed gene 3; Paternally-expressed gene 3 protein; unnamed protein product; Zinc finger and SCAN domain-containing protein 24
基因别名: AL022617; ASF-1; End4; Gcap4; KIAA0287; mKIAA0287; PEG3; PW1; Zfp102; ZKSCAN22; ZNF904; ZSCAN24
UniProt ID: (Human) Q9GZU2, (Mouse) Q3URU2
Entrez Gene ID: (Human) 5178, (Mouse) 18616